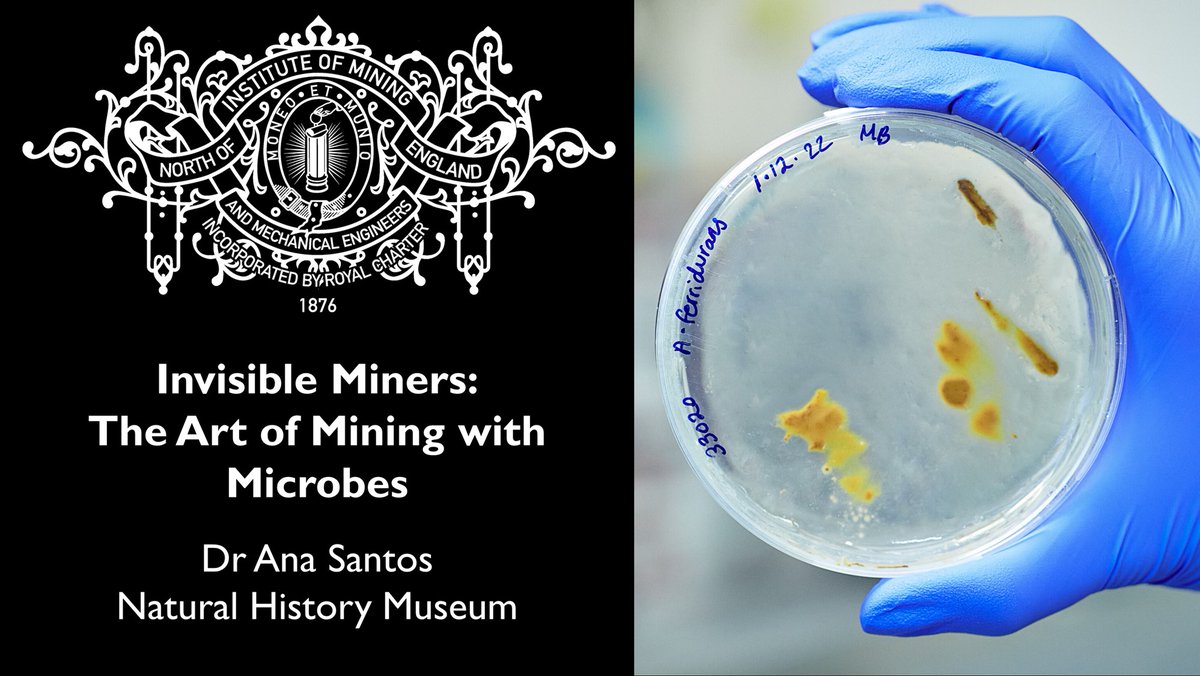
Mining Institute (@mininginstitute) on Twitter photo Our free #NEIMME Lecture on the 10th of April is given by Dr Ana Santos of <a href="/NHM_London/">Natural History Museum</a> on bioleaching valuable metals like #Cu, #Au, and #CriticalMetals from ores and waste materials, plus their role in remediation of industrial sites.
To join us see 👉eventbrite.co.uk/e/invisible-mi… Our free #NEIMME Lecture on the 10th of April is given by Dr Ana Santos of <a href="/NHM_London/">Natural History Museum</a> on bioleaching valuable metals like #Cu, #Au, and #CriticalMetals from ores and waste materials, plus their role in remediation of industrial sites.
To join us see 👉eventbrite.co.uk/e/invisible-mi…

Mining Institute
@mininginstitute
Tweets from the Newcastle Mining Institute: The Royal Chartered membership organisation for Science, Technology and Engineering in the North.
ID: 1288907923
http://www.mininginstitute.org.uk/membership/ 22-03-2013 14:53:44
2,2K Tweet
2,2K Followers
1,1K Following

Join us at NEIMME's Supporting the Future of Northern Semiconductor Industries conference on 6 June. Discover how our region is leading the way with over 30 companies and organisations driving revolutionary advancements. Sign up: eventbrite.co.uk/e/supporting-t… Mining Institute

Many congratulations to Emilia Russell, Durham University PhD Student and Mining Institute member, for winning the UK Final of the The Institute of Materials, Minerals & Mining #YPLC2024 competition! Thank you for representing our Institute in London, and many thanks to all who organised and took part in the competition.

If you'd like to hear Emilia's talk on MoS2 monolayer sensors (and why they're like crinkle cut crisps!) she'll be speaking at our #Northern #Semiconductor #Industry #Conference on the 6th of June in Newcastle! The Institute of Materials, Minerals & Mining Department of Engineering @ Durham University #YPLC2024 Details at👉 mininginstitute.org.uk/neimme-confere…

Don't miss our 6th June conference to support the future of the #Northern #Semiconductor Industry. We've a range of great speakers from #industry, academia, recruitment, #innovation, #investment and #skills providers! Full programme and registration at: mininginstitute.org.uk/neimme-confere…


Our #free May #NEIMME Lecture is on regulating #aggregate #dredging given by Emma Dowson of Marine Management Organisation ! Watch live, 6pm 23rd May 👉 youtube.com/watch?v=lHJDcL… To join us in person see👉eventbrite.co.uk/e/marine-manag…


Our Institute will hold a #Chartership Information Evening on the 30th of May on how to become #professionally chartered via the The Geological Society and The Institution of Engineering and Technology with the opportunity to ask questions on your applications during the Q&A. To register for the event see: eventbrite.co.uk/e/chartership-…






Our free December #NEIMME Lecture will cover #Quarrying's Vital Role in a Net #Zero World given by Prof David Manning of Newcastle University! Watch live, 6pm 5th December👉youtube.com/watch?v=WFs95L… To join us in person see👉eventbrite.co.uk/e/quarryings-v…



Our free January NEIMME Lecture on #Battery Metals and the Race to Net Zero given by Dr Nick Gardiner of Earth & Environmental Science, St Andrews! To join us in person see👉eventbrite.co.uk/e/battery-meta… Watch live, 6pm 23rd January👉 youtube.com/watch?v=qStMlw…



Our free #NEIMME Lecture on the 10th of April is given by Dr Ana Santos of Natural History Museum on bioleaching valuable metals like #Cu, #Au, and #CriticalMetals from ores and waste materials, plus their role in remediation of industrial sites. To join us see 👉eventbrite.co.uk/e/invisible-mi…